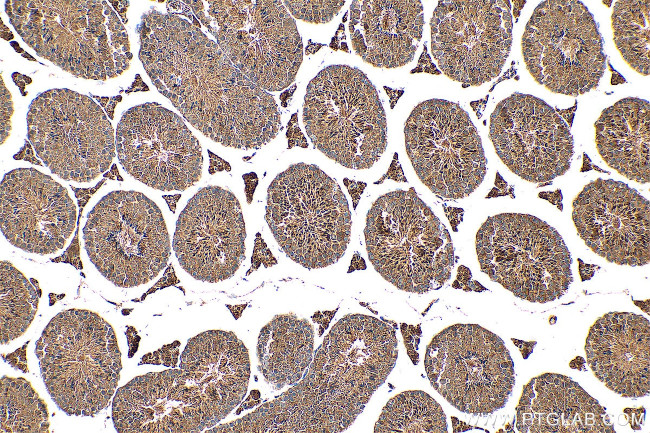
C14orf138 Antibody in Immunohistochemistry (Paraffin) (IHC (P))
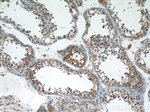
C14orf138 Antibody in Immunohistochemistry (Paraffin) (IHC (P))

Search
Proteintech
C14orf138 Polyclonal Antibody
{{$productOrderCtrl.translations['antibody.pdp.commerceCard.promotion.promotions']}}
{{$productOrderCtrl.translations['antibody.pdp.commerceCard.promotion.viewpromo']}}
{{$productOrderCtrl.translations['antibody.pdp.commerceCard.promotion.promocode']}}: {{promo.promoCode}} {{promo.promoTitle}} {{promo.promoDescription}}. {{$productOrderCtrl.translations['antibody.pdp.commerceCard.promotion.learnmore']}}
产品信息
24722-1-AP
种属反应
宿主/亚型
分类
类型
抗原
偶联物
形式
浓度
纯化类型
保存液
内含物
保存条件
运输条件
产品详细信息
Immunogen sequence: MADTLESSL EDPLRSFVRV LEKRDGTVLR LQQYSSGGVG CVVWDAAIVL SKYLETPEFS GDGAHALSRR SVLELGSGTG AVGLMAATLG ADVVVTDLEE LQDLLKMNIN MNKHLVTGSV QAKGGRNRRL SFSTRLHTDG RLHIL (1-144 aa encoded by BC105118)
靶标信息
C14orf138, also named as VCPKMT or METTL21D, is 229 amino acid protein, which belongs to the methyltransferase superfamily. C14orf138 localizes in the cytoplasm and interacts with ALKBH6. C14orf138 as a Protein-lysine N-methyltransferase that specifically trimethylates 'Lys-315' of VCP/p97; this modification may decrease VCP ATPase activity. C14orf138 exists as five isoforms. The calculated molecular weight of C14orf138 is 26 kDa, but we always detected a 46-50 kDa protein by western blot.
仅用于科研。不用于诊断过程。未经明确授权不得转售。
篇参考文献 (0)
生物信息学
蛋白别名: methyltransferase like 21D; Methyltransferase-like protein 21D; Protein N-lysine methyltransferase METTL21D; valosin containing protein lysine (K) methyltransferase; Valosin-containing protein lysine methyltransferase; VCP lysine methyltransferase; VCP-KMT
基因别名: C14orf138; METTL21D; VCP-KMT; VCPKMT
UniProt ID: (Human) Q9H867
Entrez Gene ID: (Human) 79609